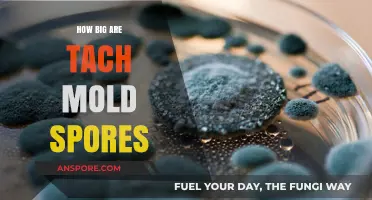
Understanding the Size of Toxic Mold Spores: A Comprehensive Guide

Bacillus spores are highly resilient structures produced by certain bacteria in the genus *Bacillus* as a survival mechanism in harsh environmental conditions. These spores are remarkably small, typically measuring between 0.5 to 1.5 micrometers (μm) in diameter, though their size can vary slightly depending on the specific species and growth conditions. Despite their microscopic dimensions, Bacillus spores are incredibly durable, capable of withstanding extreme temperatures, radiation, and desiccation, making them a subject of significant interest in fields such as microbiology, biotechnology, and environmental science. Understanding their size and structure is crucial for studying their role in bacterial survival and their potential applications in industries like food preservation and medicine.
Explore related products
What You'll Learn
- Spore Size Range: Bacillus spores typically measure 0.5 to 1.5 micrometers in diameter
- Shape and Structure: Spores are oval or cylindrical, with a multilayered protective coat
- Comparison to Bacteria: Spores are smaller than vegetative Bacillus cells, averaging 2-5 micrometers
- Measurement Techniques: Electron microscopy and light microscopy are used to determine spore size
- Size Variability: Spore size can vary based on species, growth conditions, and environmental factors

Spore Size Range: Bacillus spores typically measure 0.5 to 1.5 micrometers in diameter
Bacillus spores, the resilient dormant forms of Bacillus bacteria, are remarkably small yet play a significant role in various fields, from medicine to environmental science. Their size, typically ranging from 0.5 to 1.5 micrometers in diameter, is a critical factor in their ability to survive harsh conditions and penetrate barriers. To put this into perspective, a human hair averages about 75 micrometers in width, making these spores roughly 50 to 150 times smaller. This minuscule size allows them to remain suspended in air for extended periods, increasing their dispersal range and potential impact.
Understanding the size range of Bacillus spores is essential for designing effective filtration systems, particularly in healthcare and laboratory settings. HEPA filters, commonly used to capture airborne particles, are rated to trap particles as small as 0.3 micrometers with 99.97% efficiency. Given that Bacillus spores fall within this range, HEPA filters are highly effective at preventing their spread. However, in environments where spore concentration is high, such as in biowarfare simulations or industrial fermentation processes, additional measures like UV-C light treatment may be necessary to ensure complete deactivation.
From a biological standpoint, the size of Bacillus spores is a testament to their evolutionary efficiency. Their compact structure minimizes resource expenditure during dormancy while maximizing surface area-to-volume ratio, facilitating rapid rehydration and germination when conditions improve. This adaptability is why Bacillus spores can survive extreme temperatures, radiation, and desiccation, making them a subject of interest in astrobiology studies exploring the potential for life on other planets. For researchers, knowing the precise size range aids in developing targeted treatments, such as antimicrobial coatings or spore-specific antibodies, that can disrupt their protective outer layers.
Practical applications of this size knowledge extend to everyday scenarios, such as food preservation and water treatment. In the food industry, understanding spore dimensions helps optimize sterilization techniques like autoclaving, where temperatures of 121°C (250°F) for 15–20 minutes are required to destroy spores in canned goods. Similarly, in water treatment plants, filtration systems are calibrated to capture spores, ensuring safe drinking water. Homeowners can benefit from this knowledge by using spore-resistant air filters, particularly in mold-prone areas, to maintain indoor air quality.
Finally, the size range of Bacillus spores has implications for diagnostic techniques in clinical settings. Microscopy, while useful, often requires staining or phase-contrast methods to visualize spores due to their small size and low refractive index. Advanced techniques like flow cytometry or PCR-based assays offer higher sensitivity, enabling detection of spore concentrations as low as 10 spores per milliliter. For healthcare professionals, this precision is crucial in diagnosing spore-related infections, such as anthrax, and implementing timely interventions. In summary, the 0.5 to 1.5 micrometer size range of Bacillus spores is not just a biological curiosity but a practical parameter shaping technologies, safety protocols, and scientific inquiry.
Vacuum Mold Spores: Effective Removal Techniques and Safety Tips
You may want to see also

Shape and Structure: Spores are oval or cylindrical, with a multilayered protective coat
Bacillus spores are marvels of natural engineering, designed to withstand extreme conditions. Their shape—typically oval or cylindrical—is not arbitrary. This geometry maximizes surface area for nutrient absorption while minimizing vulnerability to environmental stressors. The oval form, slightly rounded at the ends, is particularly common in species like *Bacillus subtilis*, a well-studied model organism. Cylindrical spores, though less frequent, offer a unique balance of stability and flexibility, often observed in soil-dwelling strains. These shapes are not just structural quirks but evolutionary adaptations that ensure survival in harsh environments, from scorching deserts to deep-sea vents.
The multilayered protective coat of a bacillus spore is its secret weapon. This coat consists of several distinct layers, each serving a specific function. The outermost layer, known as the exosporium, acts as a barrier against desiccation and chemical damage. Beneath it lies the spore coat, a protein-rich layer that provides mechanical strength and resistance to enzymes. Finally, the inner membrane encapsulates the spore’s genetic material, shielding it from radiation and heat. Together, these layers create a fortress that can endure temperatures up to 100°C, prolonged UV exposure, and even the vacuum of space. For practical applications, understanding this structure is crucial—for instance, in food preservation, knowing how to penetrate these layers can improve sterilization techniques.
Comparing bacillus spores to other bacterial spores highlights their unique advantages. While *Clostridium* spores are similarly resilient, their spherical shape offers less surface area for nutrient uptake, making them less efficient in certain environments. In contrast, the elongated shape of bacillus spores allows them to navigate through soil and water more effectively, increasing their chances of finding favorable conditions for germination. This comparative edge explains why bacillus species dominate in diverse ecosystems, from agricultural soils to human gut microbiomes. For researchers and industries, this distinction is key—tailoring strategies to target the specific shape and structure of bacillus spores can enhance everything from probiotic formulations to biocontrol agents.
To visualize the scale, consider this: a typical bacillus spore measures between 0.5 to 2 micrometers in length, roughly the size of a single red blood cell. Despite their microscopic dimensions, their impact is macroscopic. For example, in healthcare, understanding spore size is critical for designing effective filtration systems in hospitals. HEPA filters, commonly used in sterile environments, must trap particles as small as 0.3 micrometers to prevent spore contamination. Similarly, in food processing, knowing spore dimensions helps optimize heat treatment protocols, ensuring that products like canned vegetables are safe for consumption. Practical tip: when sterilizing lab equipment, use an autoclave at 121°C for 15 minutes to penetrate the spore’s protective layers effectively.
Finally, the shape and structure of bacillus spores offer lessons in biomimicry. Engineers and material scientists are inspired by their multilayered design to create resilient nanomaterials. For instance, spore-inspired coatings could enhance the durability of medical implants or protect electronics in extreme conditions. In agriculture, mimicking spore structure could lead to more efficient seed coatings, improving germination rates in challenging soils. By studying these tiny survivors, we unlock innovations that transcend biology, proving that even the smallest structures can yield the biggest breakthroughs.
Do Jack Frost Mushrooms Release Spores? A Fungal Mystery Explored
You may want to see also

Comparison to Bacteria: Spores are smaller than vegetative Bacillus cells, averaging 2-5 micrometers
Bacillus spores, the resilient dormant forms of Bacillus bacteria, are significantly smaller than their vegetative counterparts. While vegetative Bacillus cells typically range from 5 to 10 micrometers in length, spores average a mere 2 to 5 micrometers. This size reduction is a critical adaptation for survival, allowing spores to withstand harsh environmental conditions that would destroy larger, more metabolically active cells.
Consider the practical implications of this size difference in laboratory settings. When culturing Bacillus species, researchers often use filtration techniques to separate spores from vegetative cells. Filters with pore sizes of 0.45 micrometers effectively retain vegetative cells while allowing smaller spores to pass through. This method, known as spore harvesting, leverages the size disparity to isolate spores for further study or application in industries like probiotics or biopesticides.
From an evolutionary perspective, the smaller size of Bacillus spores serves multiple purposes. Reduced volume minimizes surface area, limiting exposure to harmful agents like desiccation, radiation, and chemicals. Additionally, smaller spores require fewer nutrients for formation, conserving energy during stressful conditions. This efficiency underscores the spore’s role as a survival mechanism rather than a growth form, highlighting nature’s ingenuity in optimizing for endurance over expansion.
For those working in food safety or healthcare, understanding spore size is crucial. Bacillus spores, particularly those of *B. cereus* or *B. anthracis*, can contaminate food or medical equipment despite rigorous cleaning. Their small size allows them to evade detection and persist in environments where larger cells would be eliminated. Implementing heat treatments (e.g., autoclaving at 121°C for 15 minutes) or chemical disinfectants (e.g., 70% ethanol) ensures spore inactivation, as their smaller size does not inherently confer resistance to these methods—only their dormant state does.
Finally, the size comparison between spores and vegetative cells offers a lens into microbial life cycles. While vegetative cells prioritize growth and reproduction, spores embody stasis and resilience. This duality is a reminder of bacteria’s adaptability, with size serving as both a limitation and a strength depending on the phase of life. For anyone studying or managing Bacillus, recognizing this distinction is key to predicting behavior, whether in a petri dish or a production facility.
Invisible Spores: Are Our Hands Carrying Hidden Microbial Hitchhikers?
You may want to see also
Explore related products

Measurement Techniques: Electron microscopy and light microscopy are used to determine spore size
Bacillus spores, known for their resilience, range in size from 0.6 to 1.0 micrometers in diameter, with lengths varying from 0.7 to 1.5 micrometers. Accurately measuring these dimensions is crucial for research, identification, and applications in fields like medicine and environmental science. Two primary techniques dominate this task: electron microscopy and light microscopy, each offering distinct advantages and limitations.
Electron microscopy (EM) stands as the gold standard for precise spore measurement. Transmission electron microscopy (TEM) and scanning electron microscopy (SEM) provide high-resolution images, allowing researchers to discern intricate details of spore morphology. TEM, in particular, enables the visualization of internal structures, such as the spore’s core and coat layers, with resolutions down to the nanometer scale. For instance, TEM studies have revealed that Bacillus subtilis spores typically measure 0.8–1.0 micrometers in diameter. However, EM requires extensive sample preparation, including fixation, dehydration, and metal coating, which can be time-consuming and may alter spore morphology. Additionally, the high cost and specialized training needed for EM limit its accessibility for routine measurements.
Light microscopy, while less precise than EM, remains a practical and widely used alternative. Phase-contrast and bright-field microscopy allow for quick, non-invasive observation of spores in their natural state, making it ideal for live samples or large-scale screenings. Modern advancements, such as differential interference contrast (DIC) microscopy, enhance contrast and improve size estimation, though resolution is capped at approximately 200 nanometers. For example, light microscopy studies often report Bacillus anthracis spores as 1.0–1.2 micrometers in length, with slight variations depending on the strain. Despite its lower resolution, light microscopy’s simplicity, affordability, and compatibility with staining techniques (e.g., malachite green for spore coats) make it a valuable tool for preliminary assessments.
Choosing between electron and light microscopy depends on the research question and available resources. If precise measurements or structural details are critical, EM is indispensable. For rapid, cost-effective analysis or live-sample observation, light microscopy suffices. Combining both techniques can provide a comprehensive understanding of spore size and morphology. For instance, EM can confirm the dimensions identified by light microscopy, ensuring accuracy in applications like spore classification or quality control in biotechnological processes.
Practical tips for optimizing spore measurement include proper sample preparation and calibration. For light microscopy, use a calibrated micrometer slide to ensure accurate size estimation. In EM, minimize artifacts by employing gentle fixation methods, such as glutaraldehyde treatment. Additionally, consider using image analysis software to measure spores directly from micrographs, reducing human error. By leveraging the strengths of both techniques, researchers can reliably determine the size of Bacillus spores, advancing our understanding of these remarkable structures.
Ozone's Power: Can It Effectively Eliminate Bacterial Spores?
You may want to see also

Size Variability: Spore size can vary based on species, growth conditions, and environmental factors
Bacillus spores are not one-size-fits-all entities. Their dimensions can fluctuate significantly, influenced by a trio of factors: species, growth conditions, and environmental pressures. This size variability isn’t random; it’s a strategic adaptation, ensuring survival in diverse and often harsh conditions. For instance, *Bacillus subtilis* spores typically measure between 0.5 to 1.5 micrometers in diameter, while *Bacillus anthracis* spores can range from 1 to 1.5 micrometers. These differences, though subtle, are critical for identification and understanding their ecological roles.
To grasp the impact of growth conditions, consider nutrient availability. Spores formed under nutrient-rich conditions tend to be larger, as the bacterium has ample resources to invest in spore development. Conversely, nutrient deprivation often results in smaller spores, a trade-off between size and survival. Temperature also plays a pivotal role. Studies show that spores formed at higher temperatures (e.g., 37°C) are generally smaller than those formed at lower temperatures (e.g., 25°C). This temperature-dependent size variation highlights the spore’s ability to adapt to its environment even before it’s released.
Environmental factors further complicate the picture. Exposure to stressors like UV radiation, desiccation, or extreme pH levels can influence spore size. For example, spores exposed to prolonged desiccation may shrink slightly due to water loss, while those in alkaline environments might exhibit altered morphology. These changes are not merely cosmetic; they affect the spore’s durability and germination potential. A smaller spore might be more resistant to physical stress, while a larger one could store more nutrients for future growth.
Practical implications of this size variability are significant, especially in industries like food safety and medicine. In food processing, understanding spore size can help optimize sterilization techniques, as smaller spores may require more stringent conditions to be inactivated. For medical applications, spore size influences vaccine development and antibiotic efficacy. Researchers must account for these variations to ensure treatments target the correct spore morphology.
In conclusion, the size of a *Bacillus* spore is a dynamic trait, shaped by species-specific traits, growth conditions, and environmental challenges. This variability is not a flaw but a feature, enabling spores to thrive in diverse settings. By studying these differences, scientists can better predict spore behavior, improve industrial processes, and combat spore-related threats more effectively. Whether in a lab or the wild, spore size matters—and its variability is a testament to the resilience of these microscopic survivors.
Unbelievable Lifespan: How Long Can Spores Survive in Extreme Conditions?
You may want to see also
Frequently asked questions
A typical bacillus spore ranges in size from 0.5 to 1.5 micrometers (μm) in diameter, depending on the species.
No, bacillus spores are microscopic and cannot be seen with the naked eye; they require a microscope for visualization.
Bacillus spores are generally smaller than the vegetative bacterial cells they form from, which are usually 1 to 10 micrometers in length.
Yes, the size of bacillus spores can vary slightly among species, but most fall within the 0.5 to 1.5 micrometer range.
While size alone is not the primary factor, smaller spores may have a higher surface-to-volume ratio, which can influence their resistance to heat, chemicals, and other stressors. However, the spore's structure and composition play a more significant role in its durability.